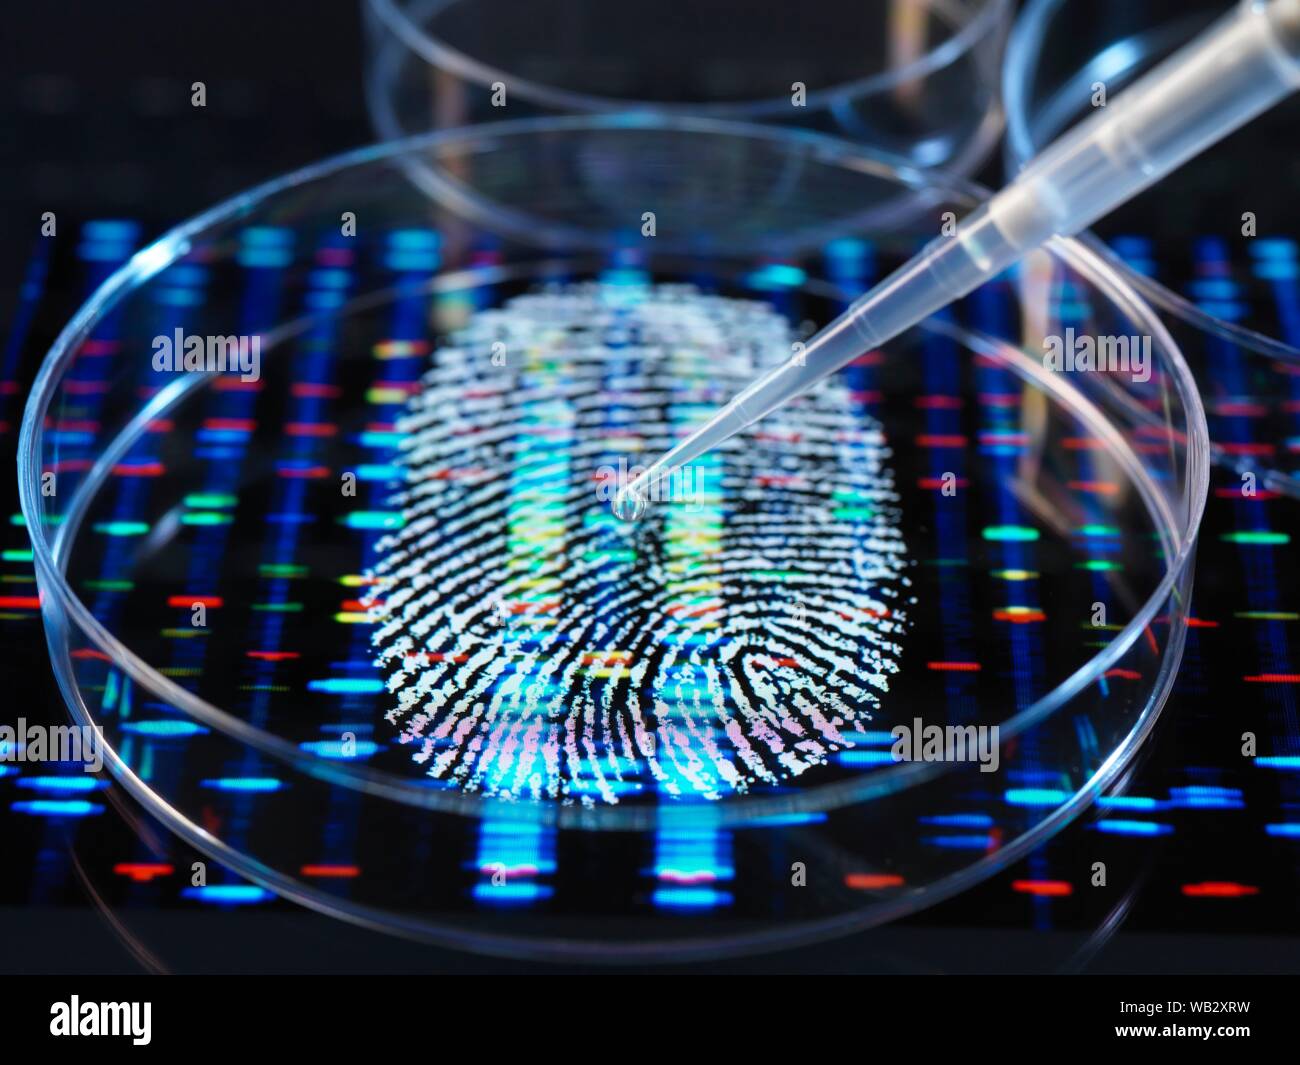
Immagine concettuale che illustra la ricerca genetica. Un dito umano stampa con un DNA (acido desossiribonucleico) sotto il profilo di un campione umano essendo pipettati in una capsula di petri. Foto Stock

Codice genetico umano Immagini Stock
(8,923)Filtri rapidi:
Codice genetico umano Immagini Stock

RF3BMT9FE–Concetto futuristico di DNA umano artificiale con biotecnologia digitale a doppia elica e codice genetico nella struttura molecolare astratta.

RMG593HP–Dettaglio di un DNA a doppia elica molecola. DNA (acido desossiribonucleico) è una molecola che porta la maggior parte del codice genetico

RM2NAP8KG–Donna medico lavora su analisi del dna umano con aiuti di simulazione al computer per esaminare il codice genetico umano in Messico

RM2JDR44N–Pforzheim, Germania. 22nd giugno 2022. Nel museo della gioielleria della Reuchlinhaus, viene mostrata l'opera "il codice genetico umano" del 2003 del duo di artisti Fischerartwork (Sandra e Uwe Fischer). Fa parte della mostra "chöngeschrieben - Schmuck, Zeichen- und Druckunst" che si può vedere dal 25.06.2022 al 06.11.2022 in occasione del 500th anniversario della morte del filosofo Johannes Reuchlin (1455-1522). Credit: Uli Deck/dpa/Alamy Live News

RFHTT536–La padronanza di evoluzione umana / 3D illustrazione della doppia elica del DNA struttura che si eleva dalla mano aperta

RF2BNCFRP–Ingegneria del DNA. Genoma crispr cas9, modifica del codice di mutazione genica. Biochimica umana e cromosomi ricerca concetto vettore. Illustrazione dell'ingegneria genetica, codice di mutazione genetico

RFG6N974–Piccolo popolo formando un elica di DNA - simbolo della ricerca genetica e popolazione ampi tratti genetici concetto
RFWB2XRW–Immagine concettuale che illustra la ricerca genetica. Un dito umano stampa con un DNA (acido desossiribonucleico) sotto il profilo di un campione umano essendo pipettati in una capsula di petri.

RMBGR4C6–Immagine simbolo di essere umano e digitalizzare, codice di riduzione di numeri, di decodifica

RMEH70EF–Illustrazione con Double helix e sagome umane come allegoria della medical codice genetico ricerche
RF2WH20R5–Icona illustrativa dei cromosomi X che rappresenta la ricerca genetica e la biologia molecolare, ideale per materiali didattici e pubblicazioni scientifiche

RF3CHT9CW–Scansione in primo piano dell'occhio umano in laboratorio biotecnologico, con codice digitale, pattern molecolare, elica rossa del DNA

RME7MAA2–DNA, impronte digitali e codice binario – identità genetica e biometria. Illustrazione digitale che simboleggia l'identità genetica, la biometria e la sicurezza informatica

RF2KDR5KE–Sezione di DNA danneggiata. Mutazioni genetiche. Disturbi genetici, deviazioni. Conferma paternità

RF2BBMA6H–3D Illustrazione molecola di DNA, la sua struttura. Concetto genoma umano. Molecola di DNA con geni modificati. Illustrazione concettuale di una molecola di dna all'interno

RF3A6MT1P–Dati genetici e sicurezza delle informazioni sul DNA personale i dati genetici violano la sicurezza e le informazioni mediche personali come DNA codice binario genoma scienza conc

RFG5MK30–Dettaglio di un DNA a doppia elica molecola. DNA (acido desossiribonucleico) è una molecola che porta la maggior parte del codice genetico

RM2JDR432–Pforzheim, Germania. 22nd giugno 2022. Nel museo della gioielleria della Reuchlinhaus, viene mostrata l'opera "il codice genetico umano" del 2003 del duo di artisti Fischerartwork (Sandra e Uwe Fischer). Fa parte della mostra "chöngeschrieben - Schmuck, Zeichen- und Druckunst" che si può vedere dal 25.06.2022 al 06.11.2022 in occasione del 500th anniversario della morte del filosofo Johannes Reuchlin (1455-1522). Credit: Uli Deck/dpa/Alamy Live News

RFJ48AH2–Siringhe di DNA concetto / 3D illustrazione della doppia elica del DNA struttura formata da siringhe medicali
RF2AYXX6P–Icone nere del vettore a spirale del DNA. Biologia segni genetici e simboli di molecole di dna per chimica o biologia

RFG6N97E–Piccolo popolo formando un elica di DNA - simbolo della ricerca genetica e popolazione ampi tratti genetici concetto

RFFKW1YX–Scienziato la visualizzazione di una sequenza di DNA su gel di capire le informazioni genetiche di un essere umano in un laboratorio

RFFKW1YY–Scienziato la visualizzazione di una sequenza di DNA su gel di capire le informazioni genetiche di un essere umano in un laboratorio

RF2JKAY19–Ricerca sul genoma del DNA. Esperimenti di laboratorio in ingegneria genetica. Decodifica del codice Helix DNA. 3D illustrazione dell'innovazione medica high tech

RM2Y16JAY–Disturbo e danno genetico del DNA, effetto mutazione o radiazione, struttura molecolare del cancro maligno, molecola di degradazione del codice genoma umano, biochimica
RF2T3FGCN–Simbolo del logo icona DNA - Gene Genetics Research Medical Science Human Health Emblem - Helix Pattern Strand Chain Infinity Concept Vector

RF2BBM62M–3D Illustrazione molecola di DNA, la sua struttura. Concetto genoma umano. Molecola di DNA con geni modificati. Illustrazione concettuale di una molecola di dna all'interno

RFF1AK6Y–Genoma la ricerca medica e la tecnologia genetica scoperte con un gruppo di medici e scienziati scalata di un filamento di DNA di scoprire una cura per la malattia umana come un simbolo della sanità medicina e biotecnologie.

RMG5MK29–Dettaglio di un DNA a doppia elica molecola. DNA (acido desossiribonucleico) è una molecola che porta la maggior parte del codice genetico

RFJ48AGY–Siringhe di DNA concetto / 3D illustrazione della doppia elica del DNA struttura formata da siringhe medicali

RF2A8DJCN–Spirale di DNA isolata. Componente del gene dell'evoluzione dell'acido desossiribonucleico vettoriale. Struttura moderna e semplice dell'elemento elicoidale genetico microbiologico su sfondo bianco

RF2BNCB1B–DNA di fondo. Struttura genetica, tecnologia biologica. poster vettoriale del modello di dna genoma umano 3d. Illustrazione dell'elica molecolare della struttura, dna genetico

RFWB2XRR–Immagine concettuale che illustra la ricerca genetica. Un dito umano stampa con un DNA (acido desossiribonucleico) sotto il profilo di un campione umano essendo pipettati in una capsula di petri.

RFKHTRN4–Coperchio o poster design con il corpo umano, scientifico e tecnologico in concetto, illustrazione vettoriale.
RF2J12WT0–Icone colorate del DNA. Struttura della molecola a spirale per la ricerca scientifica. Codice genetico umano con informazioni

RM2Y16NFJ–Disturbo e danno genetico del DNA, effetto mutazione o radiazione, struttura molecolare del cancro maligno, molecola di degradazione del codice genoma umano, biochimica

RFPXK3MG–La ricerca genetica sfondo, può essere usato come modello per un medico di presentazioni a tema. Illustrazione Digitale.
RF2T3FAAT–Simbolo del logo icona DNA - Gene Genetics Research Medical Science Human Health Emblem - Helix Pattern Strand Chain Infinity Concept Vector

RF2BBM56P–Molecola di DNA, la sua struttura. Concetto genoma umano. Molecola di DNA con geni modificati. Illustrazione concettuale di una molecola di dna all'interno di un test di vetro

RFPD5H3F–Invecchiamento del DNA scienza e salute concetto di inversione di età o la vita umana longevità concetto di biologia come una rappresentazione in 3D.

RFG593HC–Dettaglio di un DNA a doppia elica molecola. DNA (acido desossiribonucleico) è una molecola che porta la maggior parte del codice genetico

RF2AHWYYG–Incandescente e splendente di filamenti di DNA a doppia elica close-up con codice del genoma umano e il profilo di testa Medical, biologia, microbiologia, genetics 3D rendering il

RF2AEC96X–L'origine dell'essere umano. Le particelle molecolari uscente del volto al cluster nella molecola di DNA. 3D'illustrazione.

RFTX7XYP–La struttura del DNA, molecola concetto, Double helix recanti istruzioni genetiche (3d la scienza illustrazione)

RFFXW4RB–Pinnacle della specie / 3D render di figure maschili precipitando fino la doppia elica del DNA struttura

RFK6Y4D5–Artistico umano incandescente strutture cellulari con nucleo centrale raffigurante il DNA (acido desossiribonucleico) molecole.

RFWB2XTC–Immagine concettuale che illustra la ricerca genetica. Un dito umano stampa con un DNA (acido desossiribonucleico) sotto il profilo di un campione umano essendo pipettati in una capsula di petri.

RFK90YM0–Abstract il corpo umano con molecole di DNA. Medicina, la scienza e la tecnologia del concetto. Illustrazione Vettoriale.

RF2FNRTCP–Illustrazione grafica del simbolo dell'acido nucleico, abbreviato come DNA. L'acido nucleico contiene le informazioni genetiche di tutte le cose viventi.

RM2Y16RKF–Disturbo e danno genetico del DNA, effetto mutazione o radiazione, struttura molecolare del cancro maligno, molecola di degradazione del codice genoma umano, biochimica

RF2PM8G52–Origini della vita: Dalle molecole semplici al dna. Un essere umano si materializza dal dna e tiene la Terra tra le sue mani. Illustrazione digitale.

RF2PYMA68–Alta tecnologia e ricerca genetica. 3D illustrazione di un'elica di DNA su uno sfondo di codice digitale. Genoma umano, decodifica, mutazione, clonazione
RF2T3F549–Simbolo del logo icona DNA - Gene Genetics Research Medical Science Human Health Emblem - Helix Pattern Strand Chain Infinity Concept Vector

RF2BBM8MN–Molecola di DNA, la sua struttura. Concetto genoma umano. Molecola di DNA con geni modificati. Illustrazione concettuale di una molecola di dna all'interno di un test di vetro

RFTRJMHE–DNA il codice binario del genoma il concetto di scienza come un microbiologia o biochimica del computer con la tecnologia 3D'illustrazione degli elementi.

RMG5MK2M–Dettaglio di un DNA a doppia elica molecola. DNA (acido desossiribonucleico) è una molecola che porta la maggior parte del codice genetico

RF2DHY2DR–Replicazione del DNA, sintesi proteica, trascrizione e traduzione. Funzioni biologiche del DNA. Geni e genomi. Codice genetico

RFTX7XC7–La struttura del DNA, molecola concetto, Double helix recanti istruzioni genetiche (3d rendering della scienza)

RF2C5YJNG–Particelle blu di struttura del dna che si illuminano su sfondo scuro. Concetto genetico e di medicina. rendering 3d. Foto di alta qualità

RFWB2XRK–Immagine concettuale che illustra la ricerca genetica. Un dito umano stampa con un DNA (acido desossiribonucleico) sotto il profilo di un campione umano essendo pipettati in una capsula di petri.

RFK9N23K–Abstract il corpo umano con molecole di DNA. Medicina, la scienza e la tecnologia del concetto. Illustrazione Vettoriale.

RM2Y16PMT–Disturbo e danno genetico del DNA, effetto mutazione o radiazione, struttura molecolare del cancro maligno, molecola di degradazione del codice genoma umano, biochimica

RF2F9XMJX–Illustrazione che mostra la formazione di una cellula animale da dna e cromosomi. Illustrazione digitale.

RF2J8MJRT–Ricerca sul genoma del DNA. Struttura della molecola di DNA. 3D illustrazione a doppia elica. Ingegneria genetica del futuro
RF2T3FBDA–Simbolo del logo icona DNA - Gene Genetics Research Medical Science Human Health Emblem - Helix Pattern Strand Chain Infinity Concept Vector

RF2BBM7YF–3D Illustrazione molecola di DNA, la sua struttura. Concetto genoma umano. Molecola di DNA con geni modificati. Illustrazione concettuale di una molecola di dna all'interno

RF2S6PFE4–Genetica e botanica o Ingegneria genetica in Agricoltura e biotecnologia vegetale o simbolo della natura del DNA di sostenibilità e bioingegneria

RFG593HN–Dettaglio di un DNA a doppia elica molecola. DNA (acido desossiribonucleico) è una molecola che porta la maggior parte del codice genetico

RF2H3G893–Replicazione del DNA, RNA, mRNA, sintesi proteica, trascrizione e traduzione. Funzioni biologiche del DNA. Geni e genomi. Codice genetico






























